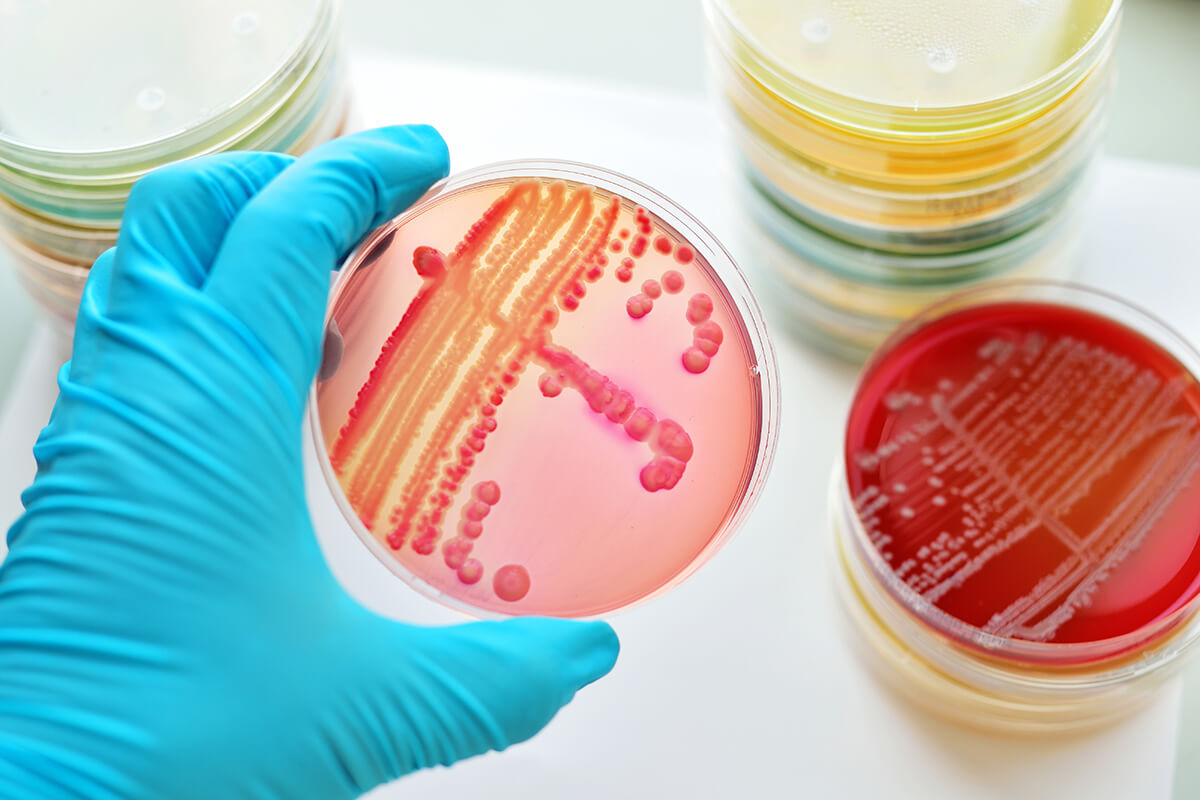
常見抗菌抗病毒的菌種庫

225 月 2023 by superlab.tw
在競爭激烈的市場中,產品是否具備「有效抗菌」的特性,已成為消費者選購時的重要考量。無論是衛生用品、紡織布料、食品包材、醫療器材或是居家用品,若能通過標準化的抗菌性測試,不僅有助於強化產品訴求,也能提升品牌信賴度。台美檢驗提供專業的抗菌測試服務,依據國際規範選用標準菌種,協助企業驗證產品是否符合抗菌效果的相關要求。
我們所提供的抗菌檢驗涵蓋革蘭氏陽性菌、陰性菌、酵母菌與黴菌等常見測試標的,包括金黃色葡萄球菌、大腸桿菌、白色念珠菌等,可依據不同測試方法如JIS、ASTM、ISO進行評估。透過嚴謹的檢驗流程與完整的技術支援,協助您準確掌握產品抗菌表現,為產品上市或法規申請做好萬全準備。
臨床菌-皮膚
- 金黃色葡萄球菌 Staphylococcus aureus
- 表皮葡萄群菌 Staphylococcus epidermidis
- 化膿性鏈球菌 Streptococcus pyogenes
- 糠秕馬拉色氏菌(皮屑芽孢菌) Malassezia furfur
- 痤瘡丙酸桿菌 Cutibacterium acnes
臨床菌-呼吸道
- 肺炎克雷伯氏菌 Klebsiella pneumoniae
- 肺炎鏈球菌 Streptococcus pneumonia
- 嗜肺退伍軍人菌 Legionella pneumophila
- 流感嗜血桿菌 Haemophilus influenza
臨床菌-腸道
- 大腸桿菌 Escherichia coli
- 腸炎弧菌 Vibrio parahaemolyticus
- 創傷弧菌 Vibrio vulnificus
- 宋內氏志賀氏菌 Shigella sonnei
- 鼠傷寒沙門氏桿菌 Salmonella enterica subsp. enterica (血清型Typhimurium)
- 霍亂弧菌 Vibrio cholera
- 大腸桿菌 O157:H7 Escherichia coli O157:H7
- 艱難梭狀芽孢桿菌 Clostridium difficile
- 幽門螺旋桿菌 Helicobacter pylori
臨床菌-口腔
- 變異鏈球菌 Streptococcus mutans
- 牙齦卟啉單胞菌 Porphyromonas gingivalis
- 伴放線凝聚桿菌 【俗稱:牙周致病菌】Aggregatibacter actinomycetemcomitans
臨床菌-泌尿生殖系統
- 腐生葡萄球菌 Staphylococcus saprophyticus
臨床菌-抗藥性菌
- 耐甲氧西林金黃色葡萄球菌 Methicillin-Resistant Staphylococcus aureus
- 多重抗藥性綠膿桿菌 Multidrug-Resistant Pseudomonas aeruginosa
環境菌
- 綠膿桿菌 Pseudomonas aeruginosa
- 產氣莢膜桿菌 Clostridium perfringens
- 仙人掌桿菌 Bacillus cereus
- 單核球增多性李斯特菌 Listeria monocytogenes
- 枯草芽孢桿菌 Bacillus subtilis subsp. spizizenii
- 梭狀芽孢桿菌 Clostridium sporogenes
- 糞腸球菌 Enterococcus faecalis
黴菌
- 黑麴菌 Aspergillus niger
- 巴西麴菌 Aspergillus brasiliensis
- 白色念珠菌 Candida albicans
- 義大利青黴菌 Penicillium italicum
- 鬚毛癬菌 Trichophyton mentagrophytes
- 球毛殼菌 Chaetomium globosumsis
更多特殊菌種檢驗或病毒檢驗可透過網站詢問聯繫。

你必須登入才能發表留言。